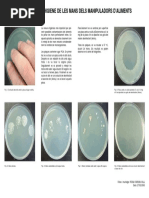

CONTROL
1
CIÈNCIES DE LA NATURALESA – 1r ESO
GRUP:
ALUMNE: DATA:
1. Escriu les tres funcions que fan els éssers vius que els diferencien dels éssers inerts. [0,3 punts]
2. Indica en cada cas a quina cèl·lula correspon. [0,8 punts]
Procariota Eucariota
Presenten molts tipus d’orgànuls cel·lulars.
Presenten aquest tipus de cèl·lules els animals i les plantes.
Un exemple són els bacteris.
No tenen nucli.
En el citoplasma només hi ha ribosomes.
Són les més petites.
El material genètic està lliure en el citoplasma.
El material genètic està envoltat per una doble membrana.
3. a) Escriu els noms de les estructures assenyalades en la imatge de la cèl·lula. [0,7 punts]
1
7
7
b) Diguis si la cèl·lula de la imatge és una cèl·lula animal o vegetal, i indica quins orgànuls són
diferents en les cèl·lules animals i les cèl·lules vegetals. [0,6 punts]
4. a) Completa la taula amb les parts del microscopi assenyalades amb un número [0,9 punts]
�
1
10
11
12
b) Relaciona quina part del microscopi correspon a la definició [0,8 punts]
Quan l’obres o el tanques varies la quantitat de llum que
1 Platina
il·lumina la mostra
2 És on es col·loca el portaobjectes amb la mostra Condensador
Caragols macromètric
3 Peça que gira i permet canviar d’objectiu
i micromètric
4 Lent a la qual s’acosta l’ull per a mirar Peu
5 Serveixen per a enfocar la mostra i poder veure-la bé Ocular
6 Cada una de les lents que estan situades al revòlver Objectiu
7 Base del microscopi Diafragma
8 Lent que concentra tota la llum en l’objecte que s’ha d’observar Revolver
c) Completa els següent quadre relatiu als augments del microscopi: [0,2 punts]
Augments de l’objectiu Augments de l’ocular Augments finals
5 x 10 x
40 x 200 x
d) En observar una mostra d’aigua d’un bassal amb el microscopi detectem uns
paramecis. En mesurem la longitud, que és de 125 µm. Si col·loquéssim 2000
paramecis en línia, quina longitud obtindríem? Expressa el resultat en µm, en mm i
en cm. Recorda que 1000 µm equivalen a 1 mm. [0,5 punts]
�
5. Indica el regne que correspon a cada definició. [0,5 punts]
Definició Regne
Són pluricel·lulars eucariotes, amb teixits. Són autòtrofs. Aquest regne
inclou les plantes sense flors i les plantes amb flors.
Són organismes unicel·lulars procariotes. N’hi ha que tenen nutrició
autòtrofa i, d’altres heteròtrofa. Inclou tots els bacteris.
Són eucariotes, de nutrició heteròtrofa. Poden ser unicel·lulars o
pluricel·lulars sense teixits. Inclou els llevats, les floridures i els bolets.
Són un grup molt variat. Tots són eucariotes. N’hi ha d’unicel·lulars i de
pluricel·lulars sense teixits. Alguns són autòtrofs (algues) i d’altres
heteròtrofs (protozous).
Són pluricel·lulars eucariotes, amb teixits. Són heteròtrofs. Pertanyen a
aquest regne els invertebrats i els vertebrats.
6. Ordena els següents grups taxonòmics de major a menor. [0,8 punts]
7. Completa el text amb les paraules següents: [1,5 punts]
gènere – fèrtils – espècie – ase – característiques – llatí – reproduir-se – espècies – mula – híbrids – científic – dues –
espècie – estèril – euga
S’anomena _________________ el conjunt d’ésses vius amb ________________ semblants que són capaços de
__________________ entre si i tenir descendents __________________. De vegades dues _______________ poden
aparellar-se i tenir descendents, però aquests no són fèrtils. Per exemple un ___________ i una ______________ poden
encreuar-se i tenir una ______________ que és _________________ . Aquests tipus de descendents s’anomenen
_________________.
El nom ____________d'una espècie està compost per la combinació de __________ paraules escrites en _______________:
el _____________ i l’___________________, per exemple Homo sapiens.
8. Explica que són els virus i per què no s’inclouen en cap dels 5 regnes. [0,4 punts]
�9. Indiqueu l’opció correcta: [2 punts]
1. Els organismes unicel·lulars que no tenen 9. Els éssers vius que estan formats per una cèl·lula
membrana nuclear que envoltin les seves s’anomenen...
molècules d’ADN es diu que són: a) pluricel·lulars
a) procariotes b) acel·lulars
b) vegetals c) unicel·lulars
c) eucariotes d) bicel·lulars
d) heterótrofs
10. Marca la resposta INCORRECTA sobre els
2. Com s’anomena la capa que delimita la cèl·lula? cloroplasts:
a) paret bacteriana a) són orgànuls presents a les cèl·lules dels teixits
b) paret de cel·lulosa verds dels vegetals
c) paret de secreció b) són de color verd a causa del pigment clorofil·la
d) membrana plasmàtica c) són responsables de fer la respiració cel·lular
dels vegetals
3. Com s’anomena el líquid gelatinós que omple la d) al seu interior es fa la fotosíntesi
cèl·lula?
a) citoplasma 11. El material genètic d’una cèl·lula està format per...
b) aigua a) AFN
c) plasma b) ADN
d) serum c) ALM
d) ADM
4. Quina de les estructures següents és exclusiva de
les cèl·lules vegetals? 12. Com s’anomena el conjunt d’organismes que
a) ribosomes poden reproduir-se entre si i donar lloc a
b) aparell de Golgi descendents fèrtils?
c) lisosomes a) població
d) paret de cel·lulosa b) comunitat
c) espècie
5. Quina de les característiques següents NO és d) ecosistema
pròpia de les cèl·lules vegetals?
a) presència de cloroplasts
13. Com s’anomena el conjunt de tots els éssers vius
b) vacúols petits que hi ha al nostre planeta i l’espai que ocupen?
c) paret gruixuda de cel·lulosa a) ecosistema
d) presència de mitocondris b) biosfera
c) població
6. Un ésser viu fabrica la matèria orgànica del seu d) comunitat
propi cos a partir de la matèria inorgànica (aigua,
sals minerals, etc). Aquest tipus de nutrició
14. Com s’anomena la branca de la Biologia que
s’anomena...
s’ocupa de classificar els éssers vius?
a) heteròtrofa
a) zoologia
b) procariota
b) taxonomia
c) autòtrofa
c) evolució
d) eucariota
d) anatomia
7. Quins organismes fan la fotosíntesi?
15. Assenyala la forma correcta d’escriure la nostra
a) només les plantes
espècie:
b) les plantes i les algues a) homo Sapiens
c) les plantes, les algues i alguns bacteris b) Homo Sapiens
d) les plantes, les algues i tots els bacteris c) Homo sapiens
d) Homo sapiens
8. La capacitat que tenen els éssers vius de captar
matèria i energia de l’entorn per créixer,
desenvolupar-se i dur a terme totes les funcions 16. Quin regne agrupa els organismes eucariotes
vitals és la funció de... unicel·lulars o pluricel·lulars, sense teixits,
a) relació heteròtrofs i amb digestió externa?
b) nutrició a) animals
c) reproducció b) fongs
d) creixement c) metafits
d) metazous
� 17. De les següents parelles d’animlas, quines tindran 19. De les següents espècies assenyala la que no
una descendència fèrtil? pertanyi a cap regne:
a) una euga i un ase a) el bacteri Escherichia coli
b) una gata i un linx b) el virus de la grip
c) una golden retiever i un pastor alemany c) el fong Penicillium roqueforti
d) una àguila i un voltor d) un pi
18. El nom científic del lleó és Panthera leo. Quin 20. Linné va dissenyar el sistema de nomenclatura
terme n’indica el gènere? binomial perquè...
a) Panthera a) els organismes tinguessin un nom singular que
b) Panthera leo sonés a llatí
c) leo b) els científics deixessin de discutir sobre els
d) lleó noms correctes dels organismes
c) existís un sistema clar i distintiu, reconegut a
tot el món
d) existís una manera de classificar subespècies
d’organismes